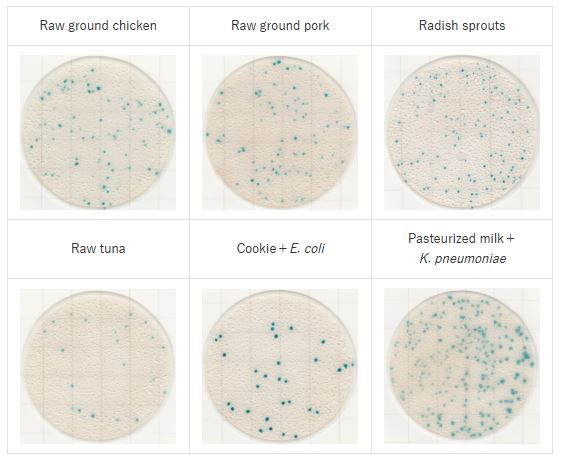
Food in easy plate CC

Film medium for coliform count | Easy Plate CC Kikkoman
1. Introduction to Easy Plate
- Easy Plate is a convenient ready-to-use medium plate that does not require preparation or sterilization. It serves as an easy-to-use alternative to traditional poured agar plates, helping save time, effort, and reduce waste.
- Easy Plate CC is a product in the Easy Plate line from Kikkoman (Japan) – a dry medium plate solution designed specifically for the detection and enumeration of Coliforms in food, beverages, and related products.
- Format: dry medium sheet, compact, easy to store and transport.
- Easy Plate CC is an AOAC PTM certified custom media formulation for detection, identification and enumeration of coliforms. A microbial test kit that includes a chromogenic substrate that causes coliforms to exhibit a distinguishable blue color allowing you to easily identify and quantify coliforms in 24±1hrs. This distinct coloring of the colonies also helps to overcome common interferences in food testing for coliforms and makes counting easier. Easy Plate CC is AOAC PTM certified and sold in packages of 100 tests in 4 separate bags containing 25 tests each. The shelf life of 18 months when stored unopened at 2-8℃.
- Display principle: coliform colonies appear as clear blue spots due to the use of the chromogenic substrate X-Gal. The plate is designed as a dry medium sheet, pre-measured and ready to use without the need for media preparation or sterilization.

2. Specifications Easy Plate CC Coliform
- Product name: Easy Plate CC medium plate
- Product code: 61974
- Application: Coliform bacteria testing. Easy Plate CC has been validated with AOAC RI PTM certification (License No. 021401).
- Incubation time: 24 ± 1 hours
- Incubation temperature: 35 ± 1℃
- Storage condition (unopened): 2–8℃
- After opening: fold the opened edge of the package at least twice, seal with tape, store in the refrigerator (2–8℃), and use within 3 months.
- Shelf life: 18 months from the date of manufacture.
3. Principle
- Easy Plate CC contains a dry, selective culture medium formulated specifically for Coliforms. When the sample is applied, the medium is dissolved and the target microorganisms grow.
- Chromogenic substances in the medium make coliform colonies clearly visible, allowing for easy observation and enumeration. Results can be evaluated directly with the naked eye, without complex equipment.
- Coliform colonies can be distinguished within 24 hours, and counting is easier than with traditional pour plate agar, since colored colonies eliminate the need to check for gas bubbles or colony size.

- Shows high correlation with pour plate methods across different food types.

- Plate surface color may be affected by enzymes in certain foods: in raw or unheated dairy products, residual enzymes may cause a blue coloration to develop across the incubation area.

4. Benefits
Compared to conventional pour plate methods, Easy Plate CC offers many outstanding benefits:
- Convenience: No media preparation or sterilization required, simply add the sample and incubate.
- Speed: Provides coliform enumeration results in 1–2 days.
- Accuracy & reproducibility: Standardized medium with strict quality control by Kikkoman.
- Space-saving: Dry plate format, stored in the refrigerator, and easier to transport than conventional agar media.
- Safe & eco-friendly: Reduces plastic and chemical waste compared to traditional media preparation.
5. Applications
Easy Plate CC is widely used in many fields:
- Food industry: microbial quality control in meat, seafood, dairy, processed products, vegetables, and fruits.
- Beverages and drinking water: microbiological quality testing in bottled water, purified water, and both sugared and sugar-free beverages.
- Pharmaceutical & cosmetic industries: coliform testing in raw materials and finished products.
- Laboratories and research institutes: used in applied microbiological studies.
6. Examples
* Strains

- Incubation conditions: 35℃, 24 hours (Diluent: phosphate buffered saline)
- These colorings are for example only.
* Foods
- Incubation conditions: 35℃, 24 hours (Diluent: phosphate buffered saline)
- These colorings are for example only.
Pacific Science Technology Euquipment Co.,LTD is the official distributor of Easy Plate products from Kikkoman in Vietnam. Please contact us for quotations and detailed product information.






